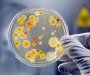

ВС 09 ноября 2015 в 18:45
Эксперты назвали несколько эффективных и необычных способов избежать болезней предстоящей зимой
ВС 07 ноября 2015 в 10:00
ВС 06 ноября 2015 в 18:41
ВС 06 ноября 2015 в 07:59
ВС 05 ноября 2015 в 18:46
ВС 05 ноября 2015 в 16:41
ВС 04 ноября 2015 в 18:41
ВС 03 ноября 2015 в 18:30
ВС 03 ноября 2015 в 11:31
ВС 02 ноября 2015 в 19:03
ВС 02 ноября 2015 в 09:35
ВС 30 октября 2015 в 18:38
ВС 29 октября 2015 в 18:35
ВС 28 октября 2015 в 18:18
ВС 27 октября 2015 в 18:10
ВС 26 октября 2015 в 18:45
ВС 26 октября 2015 в 11:43
ВС 26 октября 2015 в 07:45
ВС 23 октября 2015 в 17:15
ВС 22 октября 2015 в 17:20
ВС 21 октября 2015 в 17:30
ВС 20 октября 2015 в 17:39
ВС 20 октября 2015 в 16:33
ВС 19 октября 2015 в 17:41
ВС 16 октября 2015 в 17:58
ВС 16 октября 2015 в 15:56
ВС 15 октября 2015 в 17:35
ВС 13 октября 2015 в 17:47
ВС 13 октября 2015 в 17:40
ВС 12 октября 2015 в 18:32
ВС 12 октября 2015 в 15:52
ВС 12 октября 2015 в 06:25
ВС 09 октября 2015 в 17:29
ВС 08 октября 2015 в 18:37
ВС 07 октября 2015 в 17:52
ВС 06 октября 2015 в 17:55
ВС 05 октября 2015 в 18:04
ВС 05 октября 2015 в 06:18
ВС 02 октября 2015 в 17:40
ВС 01 октября 2015 в 17:45
ВС 30 сентября 2015 в 17:30
ВС 30 сентября 2015 в 16:49
ВС 29 сентября 2015 в 17:45
Ученые определили несколько способов, которые помогут легче перенести осеннюю хандру.
ВС 29 сентября 2015 в 14:37
ВС 28 сентября 2015 в 19:02
ВС 25 сентября 2015 в 17:47
ВС 24 сентября 2015 в 17:45
ВС 24 сентября 2015 в 16:45
ВС 23 сентября 2015 в 18:21
ВС 22 сентября 2015 в 16:55